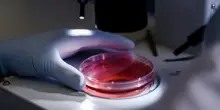
Donatore di sperma ha una mutazione genetica che aumenta il rischio di cancro, nati 200 bambini: «Alcuni sono già morti»

s

Dona sperma, i 200 bimbi nati con i suoi geni sono morti o molto a rischio: cosa non sapeva. Atroce
Oggi 10-12-25, 19:17
Una drammatica vicenda, emersa grazie a una vasta inchiesta giornalistica internazionale condotta da 14 emittenti televisive, tra cui la BBC, ha scosso profondamente il mondo della fecondazione assistita in Europa. Al centro del caso c’è un donatore di sperma, identificato con lo pseudonimo di “Kjeld”, il quale, purtroppo ignaro della sua condizione, era portatore di… Read More »Dona sperma, i 200 bimbi nati con i suoi geni sono morti o molto a rischio: cosa non sapeva. Atroce L'articolo Dona sperma, i 200 bimbi nati con i suoi geni sono morti o molto a rischio: cosa non sapeva. Atroce proviene da The Social Post.
CONTINUA A LEGGERE

3

0

0